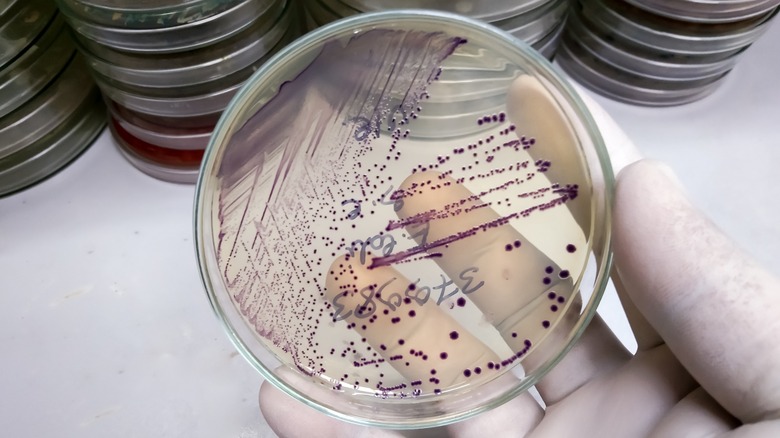

What Caused The Deadliest E. Coli Outbreak In The US?
There are a variety of bacteria that cause different types of food poisoning, but one of the most common is Escherichia coli (E. coli). While some beneficial strains of E. coli are present in human and animal digestive systems, dangerous strains can cause gastrointestinal distress, long-term illness, and even death. Produce is one of the primary carriers of the bacteria, and in 2018, it was romaine lettuce that caused the largest and deadliest outbreak in U.S. history.
This months-long outbreak ultimately caused sickness in at least 210 people, with 96 hospitalizations and five deaths. Initially, the Centers for Disease Control (CDC) advised consumers to avoid pre-cut romaine, but after an outbreak in an Alaskan correctional facility, the organization amped up its warning to include all forms of the leafy green.
The CDC ultimately determined that romaine grown in Yuma, Arizona – known as a huge producer of lettuce sold in the U.S. in the winter — was to blame. Water in a canal close lettuce farms, used for irrigation of the plants, was the most likely source of the contamination. Since the original source of lettuce is frequently not listed on the packaging in U.S., it was a challenge for consumers to discern if their greens were from the affected area. However, the outbreak ultimately subsided in June of 2018, likely due to the expiration of the last few contaminated batches.
Other notable E. coli outbreaks
Prior to 2018, there were several other deadly E. coli outbreaks in the United States. In 1993, E. coli in meat served at fast food chain Jack in the Box caused four deaths and resulted in over 700 reports of sickness, making it the second deadliest in American history. Then, in 2006, contaminated baby spinach from the brand Dole caused nearly as many illnesses and deaths as the romaine lettuce outbreak of 2018, with 205 people becoming sick, three of which died.
Vegetables contaminated with E. coli cause up to one-third of the cases of infection with the bacteria. E. coli can make its way into a plant's cell walls, and quite easily in greens like spinach and lettuce, which means that washing the veggies still may not eliminate it. And while heat can kill E. coli, it's a rare occasion that lettuce is warmed to a temperature necessary to do so. Raw sprouts are another known culprit, as is meat that hasn't been cooked to the proper temperature. Unpasteurized dairy like raw milk and cheeses may also carry the harmful bacteria.
It may be challenging to eliminate all risk of contracting food poisoning from E. coli, but there are ways to mitigate your chances of getting sick. Be sure to cook meat to the recommended temperature and consider limiting your exposure to raw dairy products and pre-cut produce, which carry underlying contamination risks. Additionally, be sure to wash your hands before eating or prepping food, or if you've been in contact with a person who has been infected.